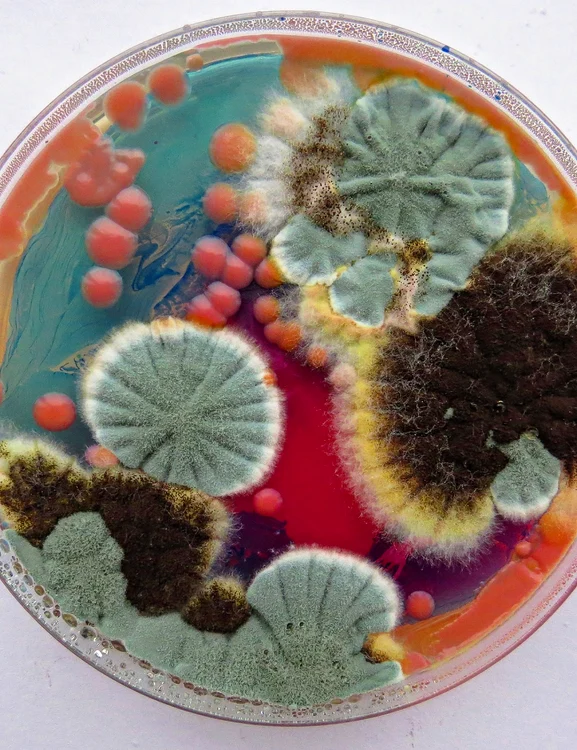
„Tablourile” sale par nişte peisaje. Foto: Profimedia

Ea face artă din mucegai. Are chiar și o listă de așteptare pentru creațiile ei
Artista Dasha Plesen, din Rusia, a stârnit controverse cu creaţiile sale neobişnuite, realizate din mucegai şi mostre de piele umană. Deşi lucrările ei pot respinge unii privitori, tânăra are numeroşi admiratori care îi apreciază stilul original şi inovator. Dasha are chiar şi o listă de aşteptare pentru creaţiile sale.

Tânăra, care are peste 310.000 de urmăritori, îşi prezintă online creaţiile colorate şi pufoase, iar fanii sunt fascinaţi, în special de unele dintre cele mai recente lucrări.
Într-un videoclip, Dasha (29 de ani) îşi introduce piciorul într-un pantof decupat în faţă, complet acoperit cu mucegai verde şi alb, cu accente de roz şi roşu.
Cunoscută drept „regina mucegaiului” şi călătorind în întreaga lume pentru a colecta mostre, artista a început să experimenteze acest tip de artă încă din anii de studenţie.

Ea a povestit că fascinaţia pentru atlasele chirurgicale, instrumentele medicale şi mediul în care viaţa este analizată în detaliu nu a dispărut, ci s-a transformat într-un limbaj artistic. Dasha Plesen recunoaşte că lucrările sale nu sunt pe gustul tuturor.
„Reacţiile sunt, de regulă, împărţite. Unii sunt fascinaţi din prima, în timp ce alţii au o reacţie puternică de respingere. Mucegaiul şi bacteriile sunt asociate, în mod obişnuit, cu contaminarea şi degradarea, aşa că e firesc ca oamenii să reacţioneze emoţional atunci când le văd într-un context artistic”, a explicat ea pentru Jam Press.
„Pentru mine, frumuseţea apare dincolo de prima reacţie. Când cineva spune că lucrările mele sunt dezgustătoare, înţeleg perfect acest lucru. Însă, dacă priveşti mai atent, de multe ori respingerea lasă loc curiozităţii. Această schimbare de percepţie este, de fapt, o parte esenţială a muncii mele”, a mai spus artista.
Lucrările ei capătă forme variate: uneori sunt realizate în recipiente de laborator speciale, folosite pentru cultivarea microorganismelor, şi amintesc de peisaje microscopice, iar alteori se transformă în piese sculpturale sau în documentări fotografice ale proceselor vii.


































